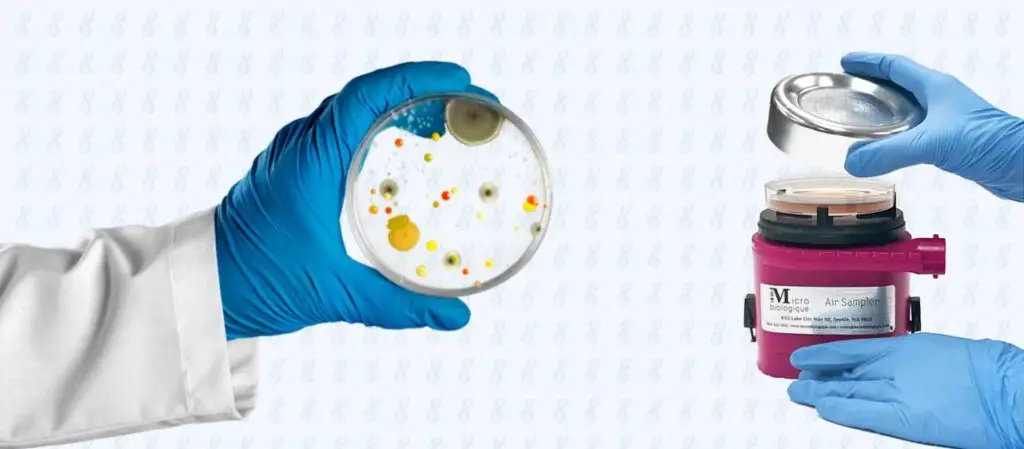
Zwei Hände in Handschuhen, eine hält Petrischale mit Bakterien hoch, eine bedient Gerät

Umfeldprobenahme: Luftkeimmessung von Luft und Druckluft
E-Learning
30 Minuten
25 € netto (29,75 € brutto)
Seminarziel/Zielgruppe:
Schulung zur Luftkeimmessung mittels Impaktion mit dem IEH Air Sampler
Die Lernziele dieser Schulung sind:
- Einführung der Luftkeimmessung
- Prinzip der Luftkeimmessung
- Spezialanwendung Druckluft
- IEH Air Sampler
- Durchführung Luftkeimmessung
- Durchführung Druckluftkeimmessung
- Mögliche Fehlerquellen
Referent/in:
Liesa Brodowski
(M. Sc. Lebensmittel- & Ernährungswissenschaften)
& Dr. Jochen Dietrich (Diplom Ökotrophologe)
Zertifikat:
Nach Absolvierung ist ein Abschlusszertifikat verfügbar.
Teilnahmebedingungen:
Der angegebene Preis versteht sich zuzüglich der gesetzlichen Mehrwertsteuer.
Nach Kauf steht Ihnen das E-Learning für 12 Monate zur Verfügung.
Um dieses E-Learning durchführen zu können, wird ein Computer oder mobiles Gerät mit Internetzugang benötigt. Zudem ist eine Registrierung auf der Lernplattform Ariana ACADEMY erforderlich.
Für den Erhalt des Teilnahmezertifikates ist ein erfolgreicher Abschluss des Wissenstestes erforderlich.
Eine Stornierung ist nur in Sonderfällen möglich, solange das E-Learning noch nicht durchgeführt wurde. Bitte wenden Sie sich hierfür per E-Mail an academy(at)alcg.eu.
Für Gruppenangebote wenden Sie sich bitte direkt an uns. Wir erstellen Ihnen gerne ein individuelles Angebot.